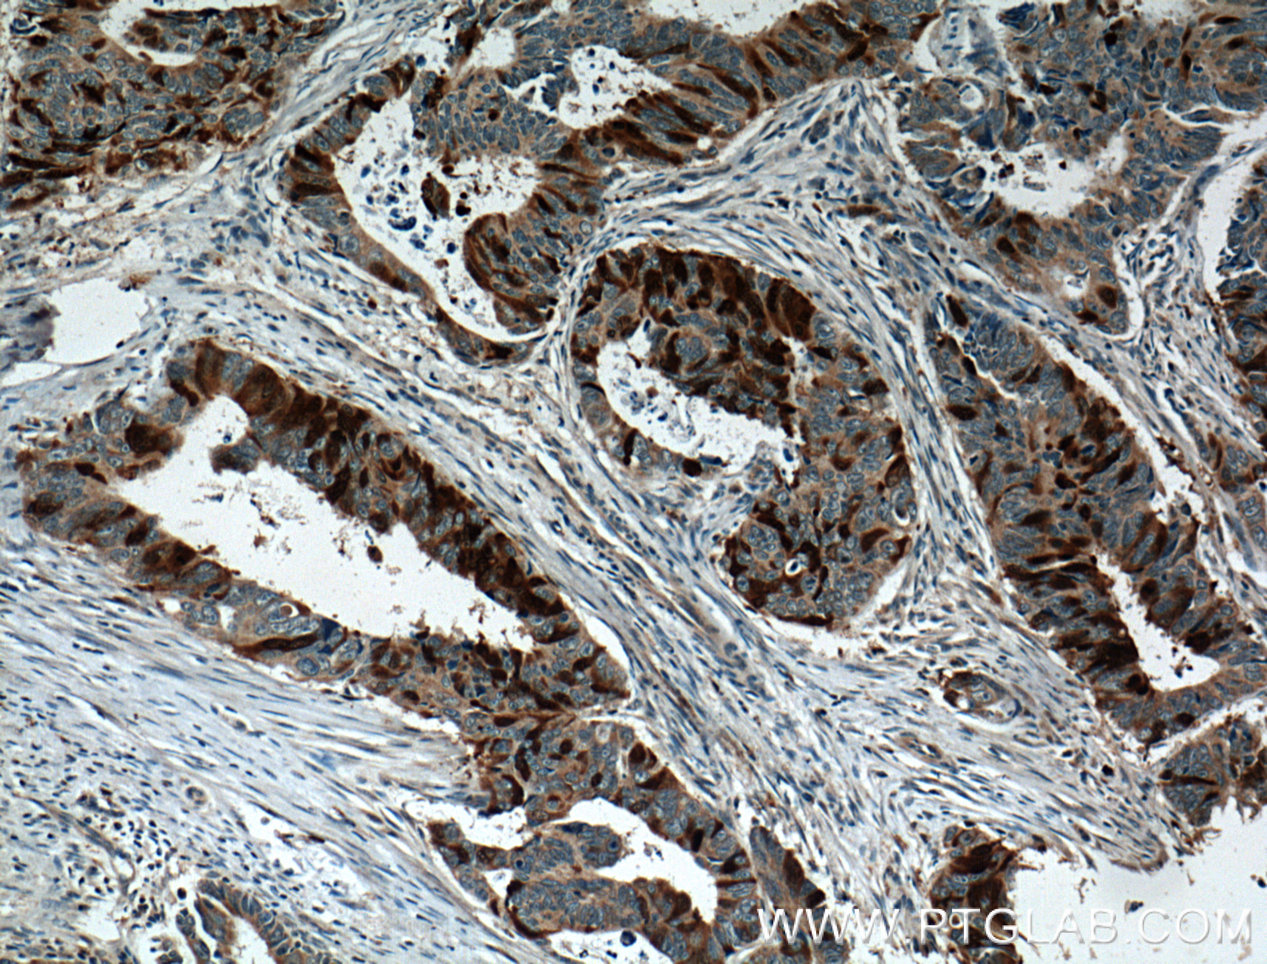
IHC宣布2PointZero Group高管任命

IHC宣布2PointZero Group高管任命

图片来源于网络,如有侵权,请联系删除
(原标题:IHC宣布2PointZero Group高管任命)
路透社11月13日消息,阿联酋国际控股公司(IHC)公布新成立的 2PointZero Group管理层,该集团由3家公司合并而成,总资产约1200亿迪拉姆。玛丽亚姆・宾特・穆罕默德・阿尔穆海里任董事总经理,负责战略方向;萨米娅・布阿扎任CEO,负责核心业务发展。

图片来源于网络,如有侵权,请联系删除
目录 返回
首页

图片来源于网络,如有侵权,请联系删除
(原标题:IHC宣布2PointZero Group高管任命)
路透社11月13日消息,阿联酋国际控股公司(IHC)公布新成立的 2PointZero Group管理层,该集团由3家公司合并而成,总资产约1200亿迪拉姆。玛丽亚姆・宾特・穆罕默德・阿尔穆海里任董事总经理,负责战略方向;萨米娅・布阿扎任CEO,负责核心业务发展。
图片来源于网络,如有侵权,请联系删除